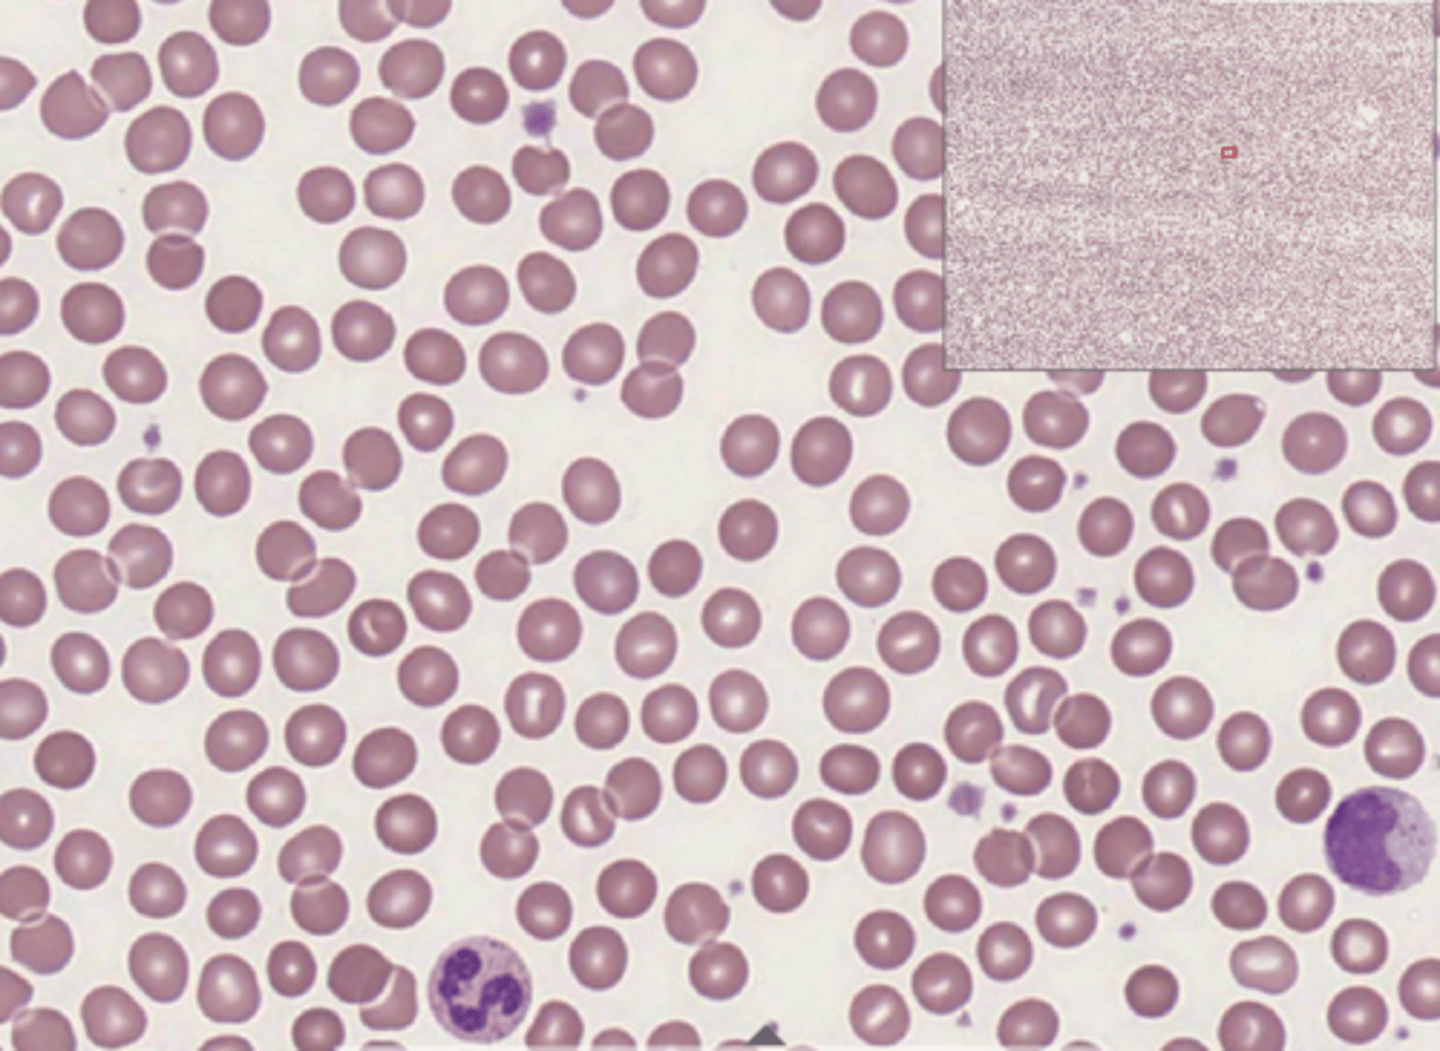
knowt flashcard image
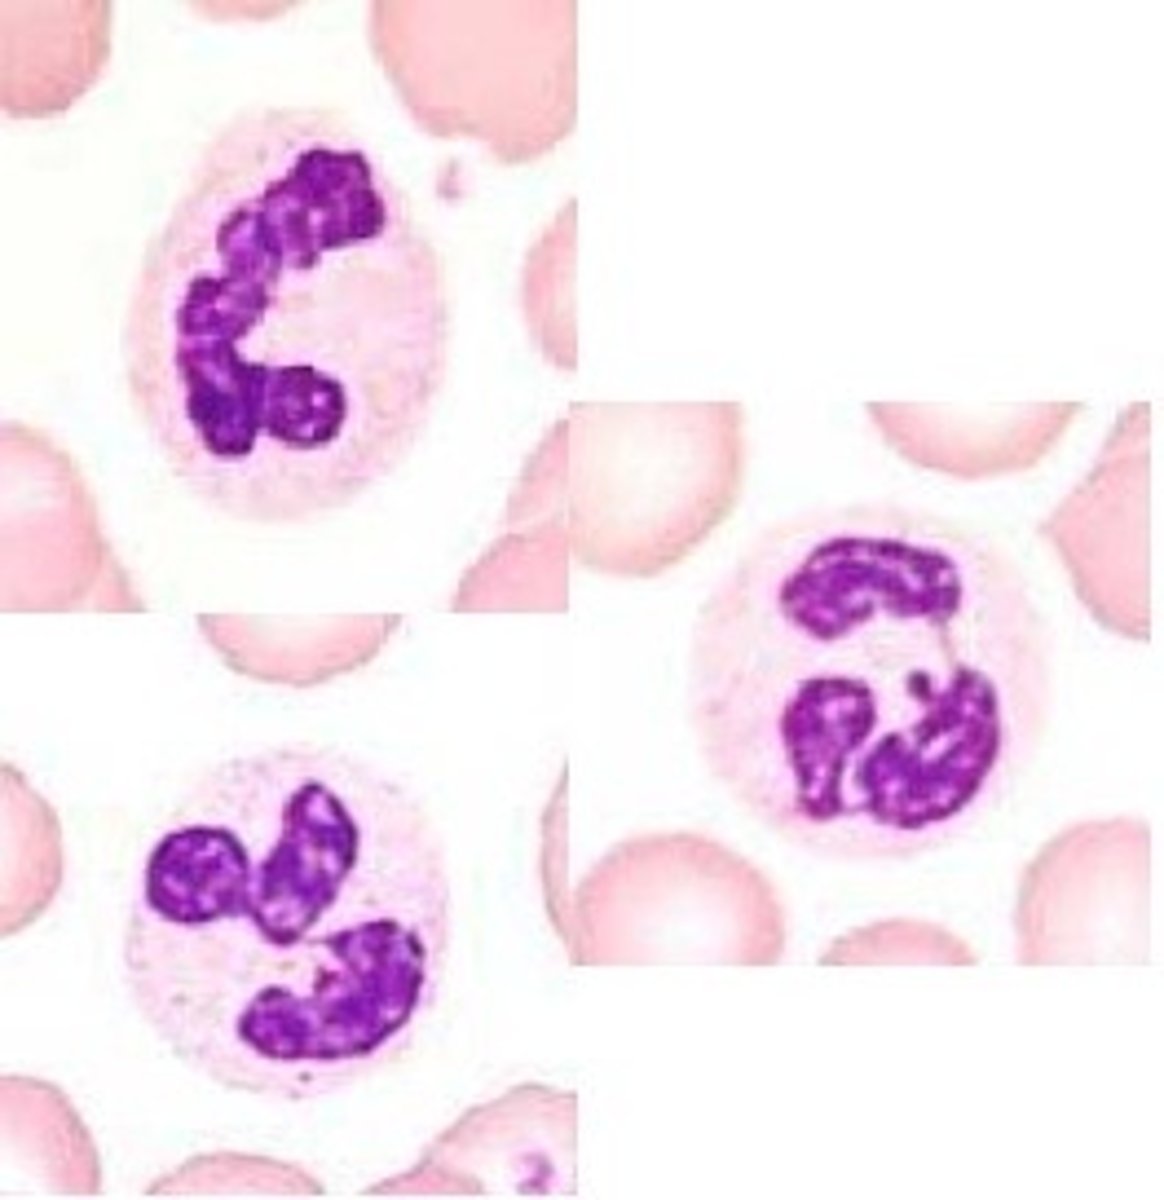
knowt flashcard image

Histology of Blood
0.0(0)
Studied by 0 peopleCard Sorting
1/6
There's no tags or description
Looks like no tags are added yet.
Last updated 1:57 AM on 3/25/26
Name | Mastery | Learn | Test | Matching | Spaced | Call with Kai |
|---|
No analytics yet
Send a link to your students to track their progress
7 Terms
1
New cards
Blood
2
New cards
Erythrocytes

3
New cards
Neutrophils
4
New cards
Eosinophils

5
New cards
Lymphocytes

6
New cards
Monocytes

7
New cards
Platelets
